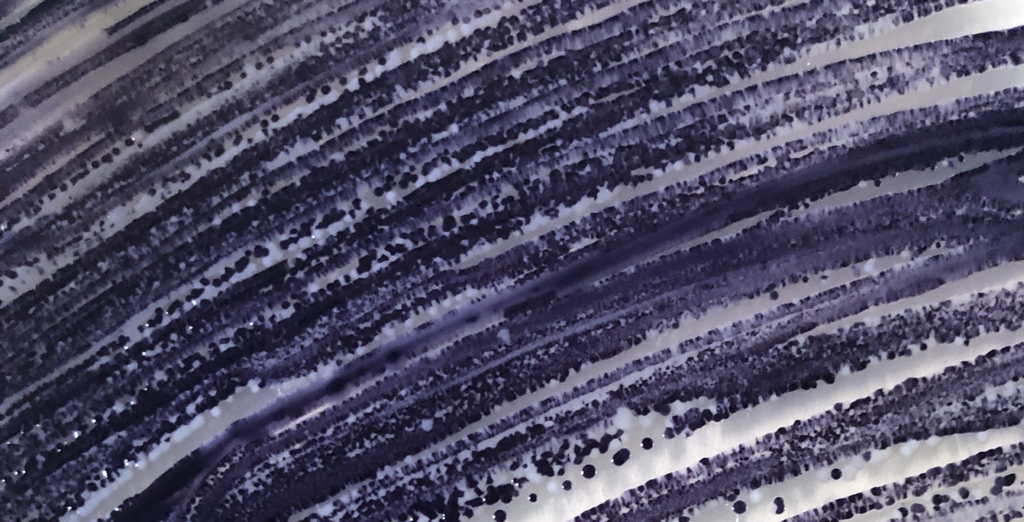

Living Colour is een innovatieve verfmethode met levende organismen. De bacteriën groeien op het textiel en laten zichtbare groeipatronen achter, die unieke dessins creëren. In het hernieuwbare verfproces worden geen schadelijke chemicaliën gebruikt en de kleur is volledig biologisch afbreekbaar. Het verven gebeurt bij lagere temperatuur en met minder water dan gebruikelijk is voor het verven van textiel. De kleur is kleurvast bij wassen, wrijven en zweten, maar zal in de loop der tijd geleidelijk vervagen bij blootstelling aan licht.
20% van alle zoetwater vervuiling wordt veroorzaakt door textiel verven en veredeling
Gemaakt van
- 100% biologisch katoen geverfd met Janthinobacterium lividum
- 100% ahimsa “peace” zijde geverfd met Janthinobacterium lividum

Productieproces
- Het textiel wordt gesteriliseerd
- De bacteriën worden aan het textiel toegevoegd
- Er wordt een voedingsbodem toegevoegd voor de bacteriën
- Na 3-4 dagen hebben de bacteriën pigment geproduceerd en het textiel geverfd

Toegepast
Een grote verscheidenheid aan materialen kan met deze verfmethode worden gekleurd, van natuurlijke vezels, tot synthetische vezels, vezel mixen en gerecyclede vezels.
Ook interessant!
De bacteriële pigmenten bevatten antimicrobiële componenten. Dit kan mogelijk een antimicrobiële kwaliteit aan het textiel geven. Goed voor de gezondheid van de huid dus.

Milieuimpact
In het hernieuwbare verfproces worden geen schadelijke chemicaliën gebruikt en de kleur is volledig biologisch afbreekbaar.
Groeimogelijkheden
Het verfproces is ambachtelijk en innovatief tegelijk. Het is momenteel nog een arbeids- en tijdsintensief labproces, geschikt voor experimentele ontwerpen.